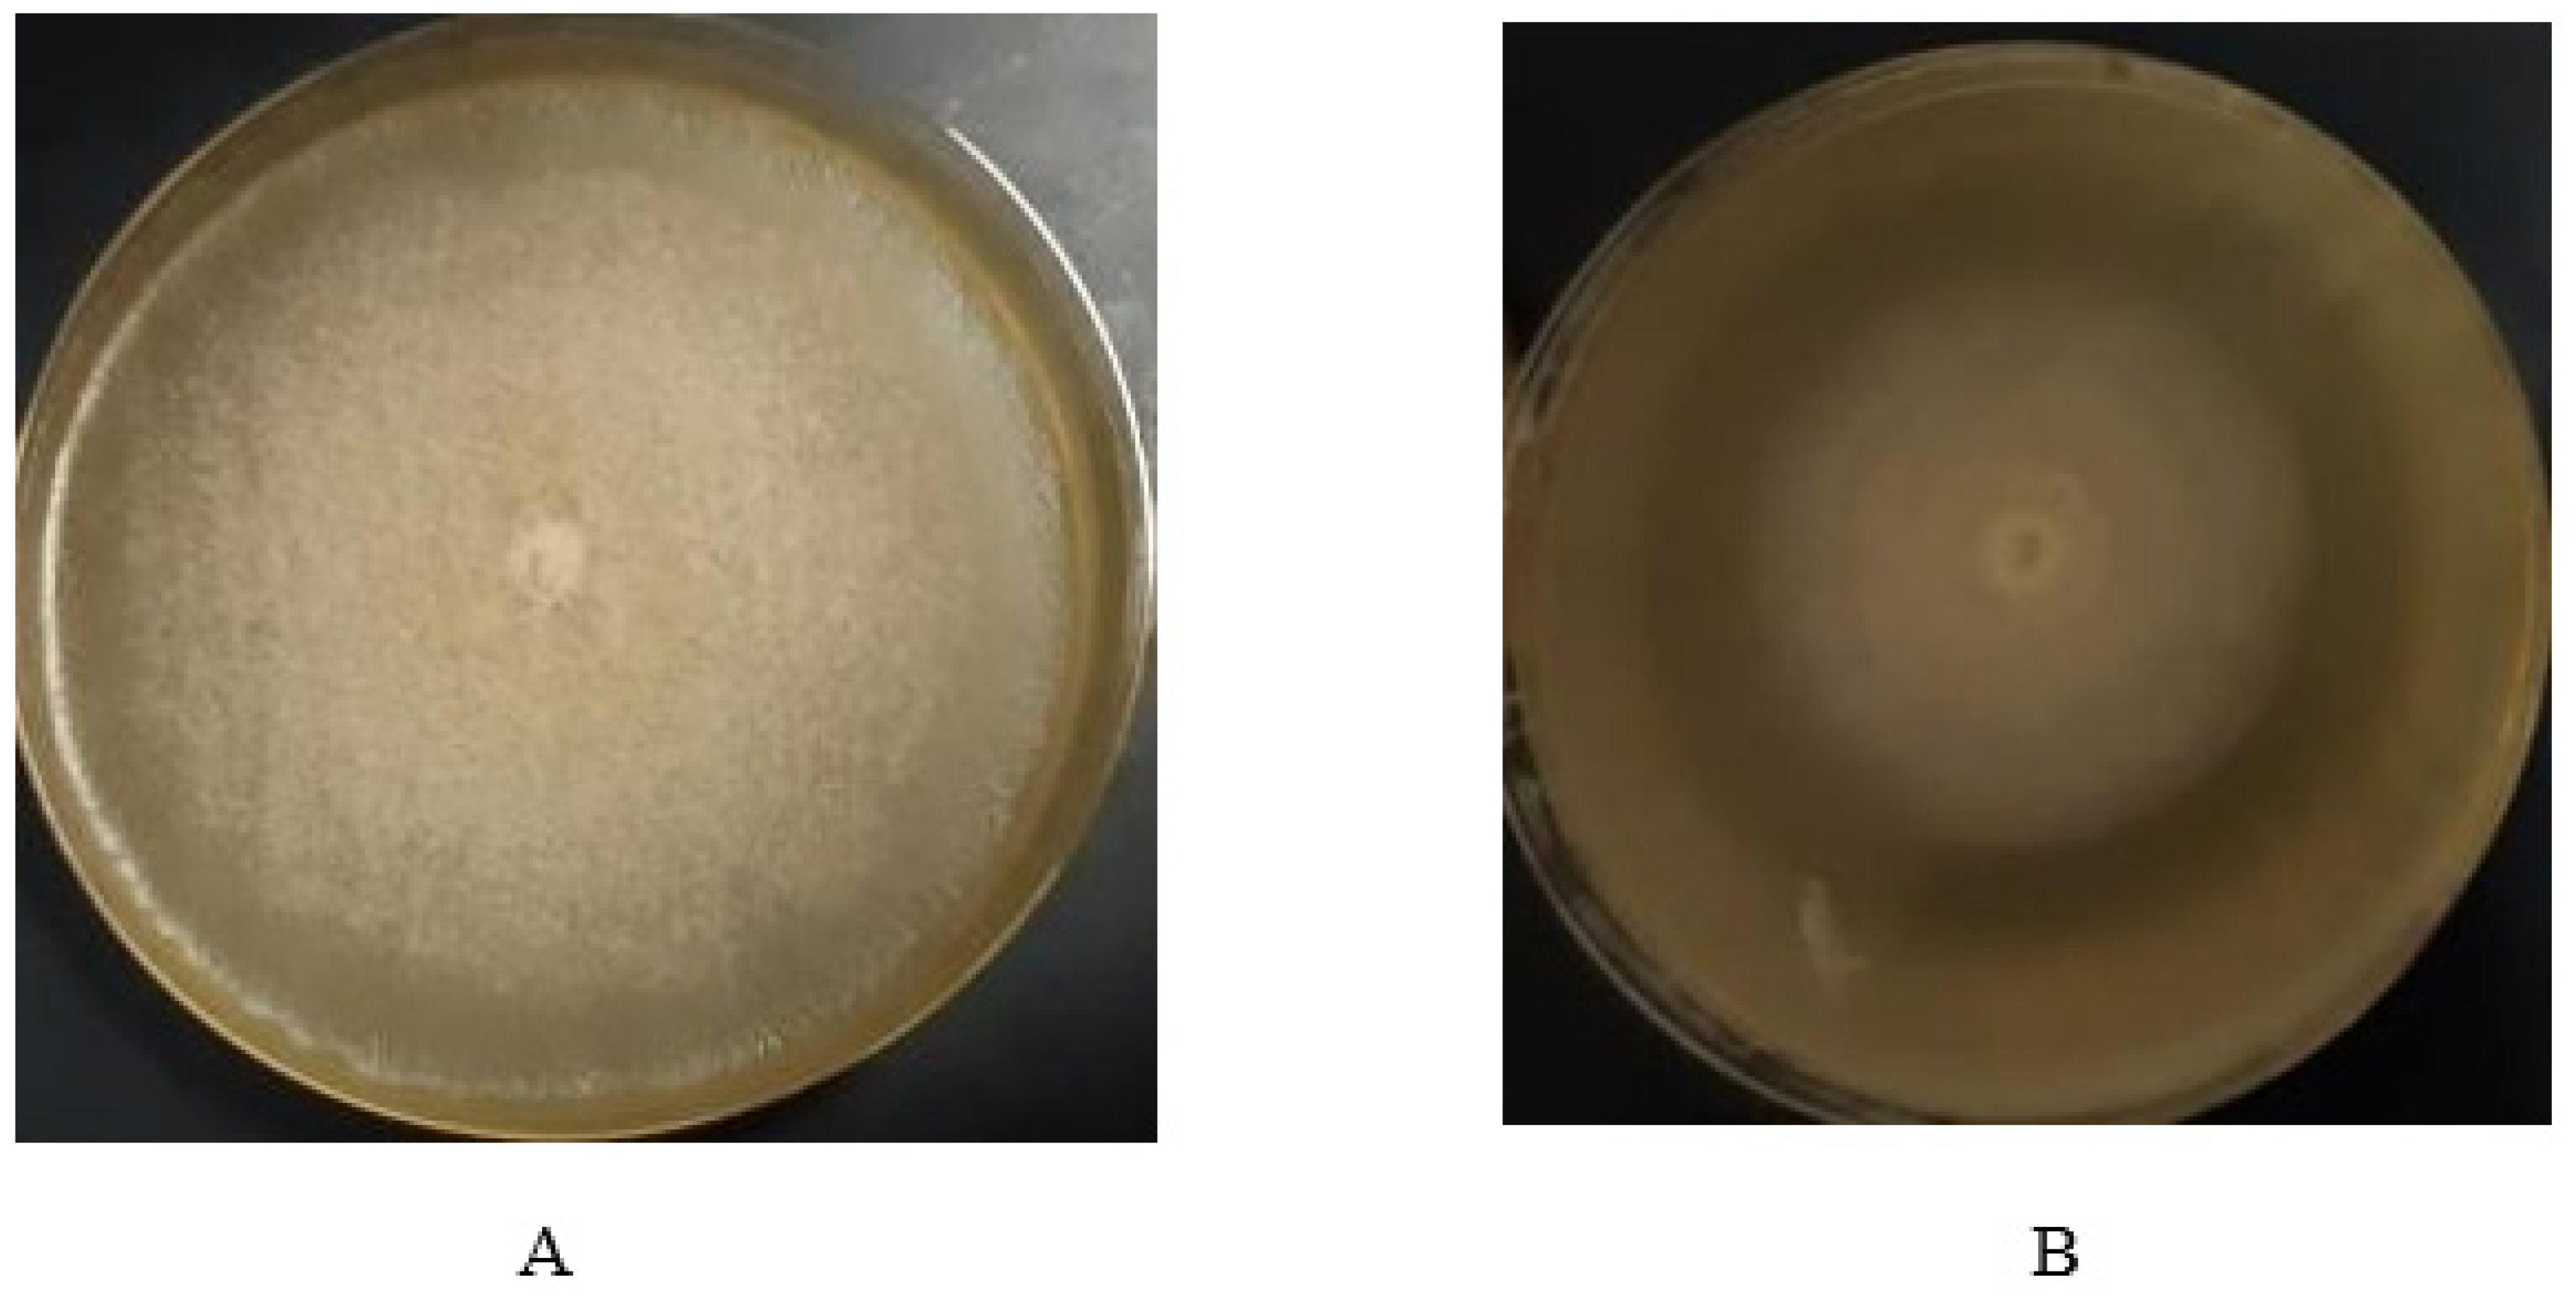
Molecules 27 02541 g001

In Vitro Investigation of the Impact of Bacterial–Fungal Interaction on Carbapenem-Resistant Klebsiella pneumoniae
Abstract
:1. Introduction
2. Material and Methods
2.1. Isolation, Identification, and Antimicrobial Susceptibility Testing of K. pneumoniae
2.2. Isolation, Screening, and Indentification of Fungi with Activity against K. pneumoniae
2.3. Fungal Bacterial Co-Culture
2.4. Subculture of K. Pneumoniae after Co-Culturing with Fungi
2.5. Next Generation Sequencing
2.6. Preparation of Crude Extract of Fungal–Bacterial Co-Culture
2.7. Testing the Crude Extract against K. pneumoniae
2.8. Column Chromatography for Compound Elucidation
2.9. Gas Chromatography Mass Spectroscopy (GC-MS)
- Injector temperature 200 °C, Temperature program: T1 = 35 °C/3 min, R1 = 10 °C/min, T2 = 220 °C
- Injector temperature 280 °C, Temperature program: T1 = 35 °C/3 min, R1 = 10 °C/min, T2 = 300 °C
2.10. Ethical Consideration
3. Results
4. Discussion
5. Conclusions
Author Contributions
Funding
Institutional Review Board Statement
Informed Consent Statement
Data Availability Statement
Conflicts of Interest
Sample Availability
References
- Conn, G.L.; Bavro, V.N. Bacterial Mechanisms of Antibiotic Resistance: A Structural Perspective. Front. Mol. Biosci. 2019, 6, 70. [Google Scholar] [CrossRef] [Green Version]
- Denkovskienė, E.; Paškevičius, Š. Broad and Efficient Control of Klebsiella Pathogens by Peptidoglycan-Degrading and Pore-Forming Bacteriocins Klebicins. Sci. Rep. 2019, 9, 15422. [Google Scholar] [CrossRef] [Green Version]
- Current State of Resistance to Antibiotics of Last-Resort in South Africa: A Review from a Public Health Perspective. Available online: https://www.ncbi.nlm.nih.gov/pmc/articles/PMC5042966/ (accessed on 30 September 2016).
- Kholy, A.E.; Baseem, H.; Hall, G.S.; Procop, G.W.; Longworth, D.L. Antimicrobial resistance in Cairo, Egypt 1999–2000: A survey of five hospitals. J. Antimicrob. Chemother. 2003, 51, 625–630. [Google Scholar] [CrossRef]
- Doron, S.; Davidson, L.E. Antimicrobial Stewardship. Mayo Clin. Proc. 2011, 86, 1113–1123. [Google Scholar] [CrossRef] [Green Version]
- El-Kholy, A.A.; Elanany, M.G.; Sherif, M.M.; Gad, M.A. High Prevalence of VIM, K. PNEUMONIAEC, and NDM Expression among Surgical Site Infection Pathogens in Patients Having Emergency Surgery. Surg. Infect. 2018, 19, 629–633. [Google Scholar] [CrossRef]
- El-Kholy, A.A.; Girgis, S.A. Molecular characterization of multidrug-resistant Gram-negative pathogens in three tertiary hospitals in Cairo, Egypt. Eur. J. Clin. Microbiol. Infect. Dis. 2020, 39, 987–992. [Google Scholar] [CrossRef] [Green Version]
- Poirel, L.; Bonnin, R.A. Genetic Features of the Widespread Plasmid Coding for the Carbapenemase OXA-48. Antimicrob. Agents Chemother. 2012, 56, 559–562. [Google Scholar] [CrossRef] [Green Version]
- Sherif, M.; Palmieri, M.; Mirande, C.; Rashed, H.G. Whole-genome sequencing of Egyptian multidrug-resistant Klebsiella pneumoniae isolates: A multi-center pilot study. Eur. J. Clin. Microbiol. Infect. Dis. Off. Publ. Eur. Soc. Clin. Microbiol. 2021, 40, 1451–1460. [Google Scholar] [CrossRef]
- Peterson, J.W. Bacterial Pathogenesis. In Medical Microbiology [Internet], 4th ed.; Baron, S., Ed.; University of Texas Medical Branch at Galveston: Galveston, TX, USA, 1996. Available online: http://www.ncbi.nlm.nih.gov/books/NBK8526/ (accessed on 28 December 2019).
- Golonka, R.; Yeoh, B.S. The Iron Tug-of-War between Bacterial Siderophores and Innate Immunity. J. Innate Immun. 2019, 11, 249–262. [Google Scholar] [CrossRef]
- Perry, R.D.; Fetherston, J.D. Yersiniabactin iron uptake: Mechanisms and role in Yersinia pestis pathogenesis. Microbes Infect. Inst. Pasteur 2011, 13, 808. [Google Scholar] [CrossRef] [Green Version]
- Diago-Navarro, E.; Chen, L.; Kodiyanplakkal, R.P. Carbapenem-resistant Klebsiella pneumoniae exhibit variability in capsular polysaccharide and capsule associated virulence traits. J. Infect. Dis. 2014, 210, 803–813. [Google Scholar] [CrossRef]
- Zheng, J.; Lin, Z.; Chen, C. Biofilm Formation in Klebsiella pneumoniae Bacteremia Strains Was Found to be Associated with CC23 and the Presence of wcaG. Front. Cell. Infect. Microbiol. 2018, 8, 21. Available online: https://www.ncbi.nlm.nih.gov/pmc/articles/PMC5829044/ (accessed on 17 February 2021). [CrossRef] [Green Version]
- Hancock, V.; Ferrières, L.; Klemm, P. The ferric yersiniabactin uptake receptor FyuA is required for efficient biofilm formation by urinary tract infectious Escherichia coli in human urine. Microbiol Read. Engl. 2008, 154, 167–175. [Google Scholar] [CrossRef] [Green Version]
- Keller, N.P.; Turner, G.; Bennett, J.W. Fungal secondary metabolism—From biochemistry to genomics. Nat. Rev. Microbiol. 2005, 3, 937–947. [Google Scholar]
- Yu, M.; Li, Y.; Banakar, S.P. New Metabolites From the Co-culture of Marine-Derived Actinomycete Streptomyces rochei MB037 and Fungus Rhinocladiella similis 35. Front. Microbiol. 2019, 10, 915. [Google Scholar] [CrossRef] [Green Version]
- Bertrand, S.; Bohni, N. Metabolite induction via microorganism co-culture: A potential way to enhance chemical diversity for drug discovery. Biotechnol. Adv. 2014, 32, 1180–1204. [Google Scholar] [CrossRef]
- Abdalla, M.A.; Sulieman, S.; McGaw, L.J. Microbial communication: A significant approach for new leads. S. Afr. J. Bot. 2017, 113, 461–470. [Google Scholar] [CrossRef]
- Bucher, T.; Oppenheimer-Shaanan, Y.; Savidor, A. Disturbance of the bacterial cell wall specifically interferes with biofilm formation. Environ. Microbiol. Rep. 2015, 7, 990–1004. [Google Scholar] [CrossRef]
- Beyda, N.D.; Lewis, R.E.; Garey, K.W. Echinocandin resistance in Candida species: Mechanisms of reduced susceptibility and therapeutic approaches. Ann. Pharmacother. 2012, 46, 1086–1096. [Google Scholar] [CrossRef]
- Moubasher, H.; Hamed, E. Anticancer Compounds from Chaetomium globosum. Biochem. Anal. Biochem. 2015, 4, 1. [Google Scholar]
- Kong, K.F.; Schneper, L.; Mathee, K. Beta-lactam Antibiotics: From Antibiosis to Resistance and Bacteriology. APMIS Acta Pathol. Microbiol. Immunol. Scand. 2010, 118, 1–36. [Google Scholar] [CrossRef] [PubMed] [Green Version]
- Nosratabadi, M.; Kordbacheh, P.; Kachuei, R.; Afshari, M.A. Isolation and Identification of Non-pathogenic and Pathogenic Fungi from the Soil of Greater Tunb, Abu-Musa and Sirri Islands, Persian Gulf, Iran. J. Appl. Biotechnol. Rep. 2017, 4, 713–800. [Google Scholar]
- Napoli, C.; Marcotrigiano, V.; Montagna, M.T. Air sampling procedures to evaluate microbial contamination: A comparison between active and passive methods in operating theatres. BMC Public Health 2012, 12, 594. [Google Scholar] [CrossRef] [PubMed] [Green Version]
- Tan, Z.Q.; Leow, H.Y. Co-Culture Systems for the Production of Secondary Metabolites: Current and Future Prospects. Open Biotechnol. J. 2019, 13, 18. [Google Scholar] [CrossRef]
- Cuenca-Estrella, M.; Gomez-Lopez, A.; Mellado, E.; Buitrago, M.J. Scopulariopsis brevicaulis, a Fungal Pathogen Resistant to Broad-Spectrum Antifungal Agents. Antimicrob. Agents Chemother. 2003, 47, 2339. [Google Scholar] [CrossRef] [Green Version]
- Lombardi, F.; Gaia, P.; Valaperta, R.; Cornetta, M.; Tejada, M.R. Emergence of Carbapenem-Resistant Klebsiella pneumoniae: Progressive Spread and Four-Year Period of Observation in a Cardiac Surgery Division. BioMed Res. International. 2015, 2015, 871947. [Google Scholar]
- Raczy, C.; Petrovski, R.; Saunders, C.T. Ultra-fast whole-genome secondary analysis on Illumina sequencing platforms. Bioinformatics 2013, 29, 2041–3000. [Google Scholar] [CrossRef] [Green Version]
- Ragheb, S.M.; Tawfick, M.M.; El-Kholy, A.A.; Abdulall, A.K. Phenotypic and Genotypic Features of Klebsiella pneumoniae Harboring Carbapenemases in Egypt: OXA-48-Like Carbapenemases as an Investigated Model. Antibiotics 2020, 9, 852. [Google Scholar] [CrossRef]
- Harvey, A.L.; Edrada-Ebel, R.; Quinn, R.J. The re-emergence of natural products for drug discovery in the genomics era. Nat. Rev. Drug Discov. 2015, 14, 111–129. [Google Scholar] [CrossRef] [Green Version]
- Nogueira, M.F.; Pereira, L.; Jenull, S. Klebsiella pneumoniae prevents spore germination and hyphal development of Aspergillus species. Sci. Rep. 2019, 18, 9. [Google Scholar] [CrossRef] [Green Version]
- Fox, E.P.; Cowley, E.S.; Nobile, C.J. Anaerobic bacteria grow within Candida albicans biofilms and induce biofilm formation in suspension cultures. Curr. Biol. CB 2014, 24, 2411–2416. [Google Scholar] [CrossRef] [PubMed] [Green Version]
- Pietikäinen, J.; Pettersson, M.; Bååth, E. Comparison of temperature effects on soil respiration and bacterial and fungal growth rates. FEMS Microbiol. Ecol. 2005, 52, 49–58. [Google Scholar] [CrossRef] [PubMed]
- Gómez, J.M.G. Aging in bacteria, immortality or not-a critical review. Curr. Aging Sci. 2010, 3, 198–218. [Google Scholar] [CrossRef]
- Ackermann, M. A functional perspective on phenotypic heterogeneity in microorganisms. Nat. Rev. Microbiol. 2015, 6, 13. [Google Scholar] [CrossRef] [PubMed]
- Zwama, M.; Yamaguchi, A. Molecular mechanisms of AcrB-mediated multidrug export. Res. Microbiol. 2018, 169, 372–383. [Google Scholar] [CrossRef]
- Nikaido, H.; Pagès, J.M. Broad-specificity efflux pumps and their role in multidrug resistance of Gram-negative bacteria. FEMS Microbiol. Rev. 2012, 36, 340–363. [Google Scholar] [CrossRef] [Green Version]
- Nolivos, S.; Cayron, J.; Dedieu, A. Role of AcrAB-TolC multidrug efflux pump in drug-resistance acquisition by plasmid transfer. Science 2019, 364, 778–782. [Google Scholar] [CrossRef]
- Bergmiller, T.; Andersson, A.M.C.; Tomasek, K. Biased partitioning of the multidrug efflux pump AcrAB-TolC underlies long-lived phenotypic heterogeneity. Science 2017, 356, 311–315. [Google Scholar] [CrossRef]
- Moubasher, M.H. Purification and Characterization of Lignin Peroxidase Isozymes from Humicola grisea (Traaen) and Its Application in Bioremediation of Textile Dyes. Egypt J. Bot. 2017, 57, 335–343. [Google Scholar] [CrossRef]
- Wakefield, J.; Hassan, H.M.; Jaspars, M.; Ebel, R.; Rateb, M.E. Dual Induction of New Microbial Secondary Metabolites by Fungal Bacterial Co-cultivation. Front. Microbiol. 2017, 8, 1284. [Google Scholar] [CrossRef] [Green Version]
- Potron, A.; Poirel, L.; Nordmann, P. Derepressed Transfer Properties Leading to the Efficient Spread of the Plasmid Encoding Carbapenemase OXA-48. Antimicrob Agents Chemother. 2014, 58, 467–471. [Google Scholar] [CrossRef] [Green Version]
- Rateb, M.E.; Houssen, W.E.; Deng, H.; Okoro, C.K. Diverse metabolic profiles of a Streptomyces strain isolated from a hyper-arid environment. J. Nat. Prod. 2011, 74, 1965–1971. [Google Scholar] [CrossRef]
- Jack, D.L.; Yang, N.M.; Saier, M.H. The drug/metabolite transporter superfamily. Eur. J. Biochem. 2001, 268, 3620–3639. [Google Scholar] [CrossRef]
- Neilands, J.B. Microbial iron compounds. Annu. Rev. Biochem. 1981, 50, 715–731. [Google Scholar] [CrossRef]
- Schubert, S.; Cuenca, S.; Fischer, D.; Heesemann, J. High-pathogenicity island of Yersinia pestis in enterobacteriaceae isolated from blood cultures and urine samples: Prevalence and functional expression. J. Infect. Dis. 2000, 182, 1268–1271. [Google Scholar] [CrossRef] [Green Version]
- Koczura, R.; Kaznowski, A. Occurrence of the Yersinia high-pathogenicity island and iron uptake systems in clinical isolates of Klebsiella pneumoniae. Microb. Pathog. 2003, 35, 197–202. [Google Scholar] [CrossRef]
- Lawlor, M.S.; O’Connor, C.; Miller, V.L. Yersiniabactin Is a Virulence Factor for Klebsiella pneumoniae during Pulmonary Infection. Infect. Immun. 2007, 75, 1463–1472. [Google Scholar] [CrossRef] [Green Version]

| AUMC No. | Identification |
|---|---|
| 1167 | Scopulariopsis brevicaulis(Saccardo) Bainier |
| 11678 | Curvularia Lunata(Wakker) Boedijn |
| 11679 | Aspergillus nigervan Tieghem |
| 11554 | Aspergillus flavus(Link) |
| 11555 | Curvularia brachyspora(Boedijn) |
| 11556 | Penicillium chrysogenum(Thom) |
| 11557 | Aspergillus flavus(Link) |
| 11559 | Penicillium chrysogepnum(Thom) |
| 11561 | Cladosporium sphaerospermumPenzig |
| 11562 | Alternaria alternate(Fries) Keissler |
| 11564 | Stemphylium botryosumWallroth |
| K. pneumoniae | K5 before Co-Culture | K5 after Co-Culture | K92 before Co-Culture | K92 after Co-Culture | K15 before Co-Culture | K15 after Co-Culture | K14 before Co-Culture | K14 after Co-Culture | K16 before Co-Culture | K16 after Co-Culture | |
|---|---|---|---|---|---|---|---|---|---|---|---|
| Antibiotic | |||||||||||
| Imipenem (IMP) | 11 mm (R) | 25 mm (R) | 9 mm (R) | 23 mm (S) | 9 mm (R) | 9 mm (R) | 10 mm (R) | 10 mm (R) | 8 mm (R) | 8 mm (R) | |
| Meropenem (MEM) | 6 (R) | 20 mm (R) | 6 (R) | 19 mm (S) | 6 (R) | 6 (R) | 6 (R) | 6 (R) | 6 (R) | 6 (R) | |
| Piperacillin/Tazobactam (TZP) | 6 (R) | 20 mm (R) | 6 (R) | 21 mm | 6 (R) | 6 (R) | 6 (R) | 6 (R) | 6 (R) | 6 (R) | |
| Cefepime (FEP) | 6 (R) | 12 mm (R) | 6 (R) | 12 mm | 6 (R) | 6 (R) | 6 (R) | 6 (R) | 6 (R) | 6 (R) | |
| Cefotaxime (CRO) | 6 (R) | 6 (R) | 6 (R) | 6 (R) | 6 (R) | 6 (R) | 6 (R) | 6 (R) | 6 (R) | 6 (R) | |
| Cefotaxime (CTX) | 6 (R) | 6 (R) | 6 (R) | 6 (R) | 6 (R) | 6 (R) | 6 (R) | 6 (R) | 6 (R) | 6 (R) | |
| Amoxicillin/Clavulanate (AMC) | 6 (R) | 15 mm (S) | 6 (R) | 16 mm | 6 (R) | 6 (R) | 6 (R) | 6 (R) | 6 (R) | 6 (R) | |
| Ceftriaxone (CRO) | 6 (R) | 6 (R) | 6 (R) | 6 (R) | 6 (R) | 6 (R) | 6 (R) | 6 (R) | 6 (R) | 6 (R) | |
| Trimethoprim-sulfamethoxazole (SXT) | 6 (R) | 17 (R) | 6 (R) | 20 mm | 6 (R) | 6 (R) | 6 (R) | 6 (R) | 6 (R) | 6 (R) | |
| Ciprofloxacin (CIP) | 6 (R) | 6 (R) | 6 (R) | 6 (R) | 6 (R) | 6 (R) | 6 (R) | 6 (R) | 6 (R) | 6 (R) | |
| Sample | Genome Accession |
|---|---|
| K5_BEFORE | JAHTMJ000000000 |
| K5_AFTER | JAHTMI000000000 |
| K14_BEFORE | JAHTMF000000000 |
| K14_AFTER | JAHTME000000000 |
| K15_BEFORE | JAHTMD000000000 |
| K15_AFTER | JAHTMC000000000 |
| K16_BEFORE | JAHTMB000000000 |
| K16_AFTER | JAHTMA000000000 |
| K92_BEFORE | JAHTMH000000000 |
| K92_AFTER | JAHTMG000000000 |
| Resistance Genes | Phenotype | K5 before (ST 101) | K5 after (ST 101) | K92 before (ST 101) | K92 after (ST 101) | K14 before (ST 383) | K14 after (ST 383) | K15 before (ST 147) | K15 after (ST 147) | K16 after (ST 383) | K16 before (ST 383) |
|---|---|---|---|---|---|---|---|---|---|---|---|
| aph(3′)-Ia | Aminoglycoside resistance | + | + | + | + | _ | _ | + | + | + | + |
| aac(6′)Ib-cr | Fluoroquinolone And aminoglycoside resistance | _ | _ | _ | _ | _ | _ | + | + | + | + |
| aph(3′)-VIa | Aminoglycoside resistance | _ | _ | _ | _ | _ | _ | _ | _ | + | + |
| aph(3′)-VIb | Aminoglycoside resistance | _ | _ | _ | _ | + | + | _ | _ | _ | _ |
| aadA1 | Aminoglycoside resistance | _ | _ | _ | _ | _ | _ | _ | _ | + | + |
| armA | Aminoglycoside resistance | + | + | + | + | _ | _ | + | + | + | + |
| strA | Aminoglycoside resistance | + | _ | + | + | + | + | + | + | + | + |
| strB | Aminoglycoside resistance | + | _ | + | + | + | + | + | + | + | + |
| fosA | Fosfomycin resistance | + | + | + | + | + | + | + | + | + | + |
| sul1 | Sulphonamide resistance | + | + | + | + | _ | _ | + | + | + | + |
| sul2 | Sulphonamide resistance | + | + | + | + | _ | _ | + | + | + | + |
| dfrA5 | Trimethoprim resistance | + | + | + | + | _ | _ | + | + | + | + |
| tet(A) | Tetracycline resistance | _ | _ | _ | _ | + | + | _ | _ | + | + |
| catA1 | Phenicol resistance | _ | _ | _ | _ | + | + | _ | _ | _ | _ |
| oqxA | Quinolone resistance | + | + | + | + | + | + | + | + | + | + |
| oqxB | Quinolone | + | + | + | + | + | + | + | + | + | + |
| QnrS1 | Quinolone resistance | _ | _ | _ | _ | _ | _ | + | + | + | + |
| QnrB1 | Quinolone resistance | _ | _ | _ | _ | _ | _ | _ | _ | + | + |
| blaCTX-M-14b | Betalactam resistance | + | _ | + | __ | + | + | + | + | + | + |
| blaCTX-M-15 | Betalactam resistance | + | + | + | + | _ | _ | + | + | + | + |
| blaTEM-1B | Betalactam resistance | _ | _ | _ | _ | _ | _ | _ | _ | + | + |
| blaOXA-48 | Betalactam resistance | + | __ | + | _ | + | + | + | + | + | + |
| blaSHV-1 | Betalactam resistance | + | + | + | + | + | + | _ | _ | + | + |
| blaSHV-12 | Betalactam resistance | _ | _ | _ | _ | _ | _ | + | + | _ | _ |
| blaNDM-5 | Betalactam resistance | _ | _ | _ | _ | _ | _ | _ | _ | + | + |
| blaOXA-9 | Betalactam resistance | _ | _ | _ | _ | _ | _ | _ | _ | + | + |
| catA1 | Phenicol resistance | _ | _ | _ | _ | _ | _ | _ | _ | + | + |
| Plasmid replicons | K5 before (ST 101) | K5 after (ST 101) | K92 before (ST 101) | K92 after (ST 101) | K14 before (ST 383) | K14 after (ST 383) | K15 before (ST 147) | K15 after (ST 147) | K16 after (ST 383) | K16 before (ST 383) | |
| IncFIB(Mar) | + | + | + | + | _ | _ | + | + | + | + | |
| IncL/M(pOXA- 48) | + | __ | + | _ | + | + | + | + | + | + | |
| IncFIB(pKPHS1) | + | + | + | + | + | + | + | + | _ | _ | |
| IncHI1B | + | + | + | + | _ | _ | + | + | + | + | |
| IncFII(pKPX1) | _ | _ | _ | _ | _ | _ | + | + | _ | _ | |
| IncFIB(pQil) | _ | _ | _ | _ | _ | _ | _ | _ | + | + | |
| IncFII(K) | _ | _ | _ | _ | _ | _ | _ | _ | + | + |
| Fraction | Weight in mg |
|---|---|
| Fraction 1 | 4.31 mg |
| Fraction 2 | 17 mg |
| Fraction 3 | 20 mg |
| Fraction 4 | 16 mg |
| Fraction 5 | 31 mg |
| Fraction 6 | 33 mg |
| Fraction 7 | 62 mg |
Publisher’s Note: MDPI stays neutral with regard to jurisdictional claims in published maps and institutional affiliations. |
© 2022 by the authors. Licensee MDPI, Basel, Switzerland. This article is an open access article distributed under the terms and conditions of the Creative Commons Attribution (CC BY) license (https://creativecommons.org/licenses/by/4.0/).
Share and Cite
Moubasher, H.; Elkholy, A.; Sherif, M.; Zahran, M.; Elnagdy, S. In Vitro Investigation of the Impact of Bacterial–Fungal Interaction on Carbapenem-Resistant Klebsiella pneumoniae. Molecules 2022, 27, 2541. https://doi.org/10.3390/molecules27082541
Moubasher H, Elkholy A, Sherif M, Zahran M, Elnagdy S. In Vitro Investigation of the Impact of Bacterial–Fungal Interaction on Carbapenem-Resistant Klebsiella pneumoniae. Molecules. 2022; 27(8):2541. https://doi.org/10.3390/molecules27082541
Chicago/Turabian StyleMoubasher, Hani, Amani Elkholy, May Sherif, Mariam Zahran, and Sherif Elnagdy. 2022. "In Vitro Investigation of the Impact of Bacterial–Fungal Interaction on Carbapenem-Resistant Klebsiella pneumoniae" Molecules 27, no. 8: 2541. https://doi.org/10.3390/molecules27082541
APA StyleMoubasher, H., Elkholy, A., Sherif, M., Zahran, M., & Elnagdy, S. (2022). In Vitro Investigation of the Impact of Bacterial–Fungal Interaction on Carbapenem-Resistant Klebsiella pneumoniae. Molecules, 27(8), 2541. https://doi.org/10.3390/molecules27082541

